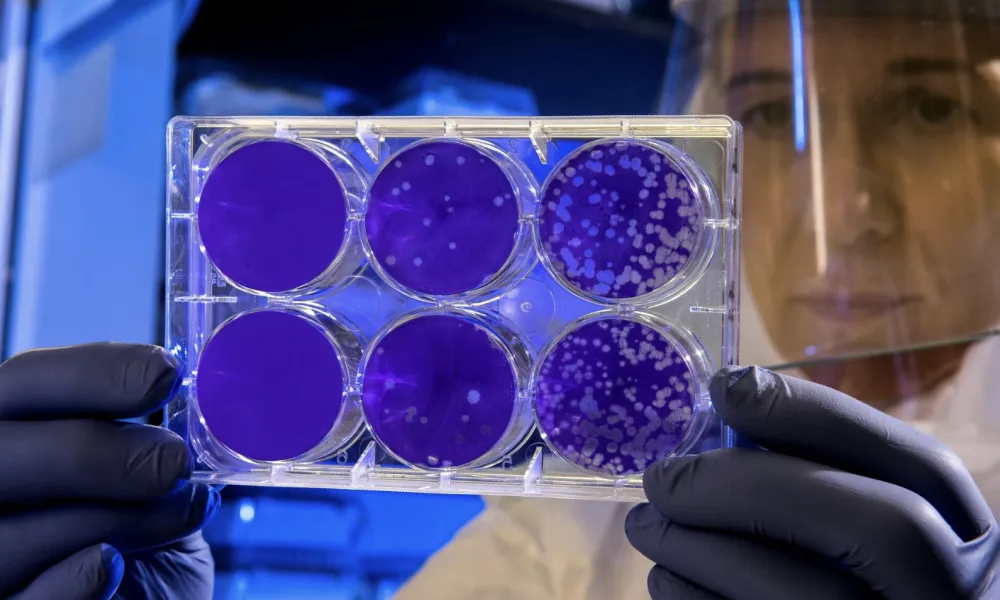
Header Image

Η Ινδία παλεύει να περιορίσει ένα ξέσπασμα του ιού Nipah στην ανατολική πολιτεία της Δυτικής Βεγγάλης, μετά την επιβεβαίωση τουλάχιστον πέντε κρουσμάτων, μεταξύ των οποίων γιατροί και νοσηλευτές που μολύνθηκαν.
Τουλάχιστον 100 άτομα έχουν κληθεί να παραμείνουν σε κατ’ οίκον καραντίνα, ενώ οι μολυσμένοι ασθενείς νοσηλεύονται σε νοσοκομεία μέσα και γύρω από την πρωτεύουσα Καλκούτα, σύμφωνα με τοπικά μέσα ενημέρωσης, με έναν ασθενή να βρίσκεται σε κρίσιμη κατάσταση.
Ο Nipah είναι ένας θανατηφόρος ιός, για τον οποίο δεν υπάρχει εμβόλιο ή θεραπεία, και θεωρείται παθογόνος οργανισμός υψηλού κινδύνου από τον Παγκόσμιο Οργανισμό Υγείας.
Οι ειδικοί αναφέρουν ότι οι ανθρώπινες λοιμώξεις είναι σπάνιες και συνήθως συμβαίνουν όταν ο ιός μεταδίδεται από νυχτερίδες, συχνά μέσω μολυσμένων φρούτων.
Όλα όσα πρέπει να γνωρίζετε για τον ιό:
Ποια είναι τα συμπτώματα;
Η λοίμωξη από τον ιό Nipah ξεκινά συνήθως με όχι τόσο συγκεκριμένα συμπτώματα, γεγονός που καθιστά δύσκολη την έγκαιρη διάγνωση.
Σύμφωνα με τα Κέντρα Ελέγχου και Πρόληψης Νοσημάτων των ΗΠΑ (CDC), η περίοδος επώασης εκτιμάται ότι κυμαίνεται από τέσσερις έως 21 ημέρες, αν και σε σπάνιες περιπτώσεις σε προηγούμενες επιδημίες έχουν αναφερθεί μεγαλύτερες καθυστερήσεις μεταξύ της έκθεσης και της εμφάνισης της νόσου.
Οι ασθενείς συνήθως εμφανίζουν αιφνίδια συμπτώματα που μοιάζουν με γρίπη, όπως πυρετό, πονοκέφαλο, μυϊκούς πόνους και κόπωση. Σε ορισμένες περιπτώσεις παρουσιάζονται και αναπνευστικά συμπτώματα, όπως βήχας, δύσπνοια ή πνευμονία, αν και ο χρόνος εμφάνισης και η σοβαρότητά τους διαφέρουν σημαντικά.
Η σοβαρότερη και πιο χαρακτηριστική επιπλοκή της λοίμωξης είναι η φλεγμονή του εγκεφάλου, γνωστή ως εγκεφαλίτιδα. Νευρολογικά συμπτώματα, όπως σύγχυση, διαταραχές της συνείδησης, επιληπτικές κρίσεις ή κώμα, εμφανίζονται συνήθως λίγες ημέρες έως εβδομάδες μετά την αρχική εκδήλωση της νόσου.
Ορισμένοι ασθενείς μπορεί επίσης να εμφανίσουν μηνιγγίτιδα.
Πόσο θανατηφόρος είναι ο ιός Nipah;
Ο ιός Nipah συνδέεται με υψηλό ποσοστό θνησιμότητας, που κυμαίνεται μεταξύ 40% και 75%, ανάλογα με το στέλεχος του ιού.
Σύμφωνα με ενημέρωση της Υπηρεσίας Ασφάλειας Υγείας του Ηνωμένου Βασιλείου, οι επιζώντες ενδέχεται να εμφανίσουν μακροχρόνιες νευρολογικές επιπτώσεις, όπως επίμονες κρίσεις ή αλλαγές στην προσωπικότητα.
Σε σπάνιες περιπτώσεις έχει αναφερθεί επανεμφάνιση εγκεφαλίτιδας μήνες ή ακόμη και χρόνια μετά την αρχική μόλυνση, είτε λόγω υποτροπής είτε λόγω επανενεργοποίησης του ιού.
Πώς μεταδίδεται ο ιός Nipah;
Ο ιός Nipah είναι ζωονοσογόνος, δηλαδή μπορεί να μεταδοθεί από τα ζώα στον άνθρωπο αλλά και από άνθρωπο σε άνθρωπο, σύμφωνα με τον Παγκόσμιο Οργανισμό Υγείας.
Οι βασικοί φυσικοί φορείς είναι οι νυχτερίδες των φρούτων (είδη Pteropus). Οι άνθρωποι μπορούν να μολυνθούν μέσω άμεσης επαφής με μολυσμένες νυχτερίδες ή άλλα ζώα, ή καταναλώνοντας τρόφιμα που έχουν μολυνθεί με σάλιο, ούρα ή κόπρανα νυχτερίδων.
Με πληροφορίες από The Independent